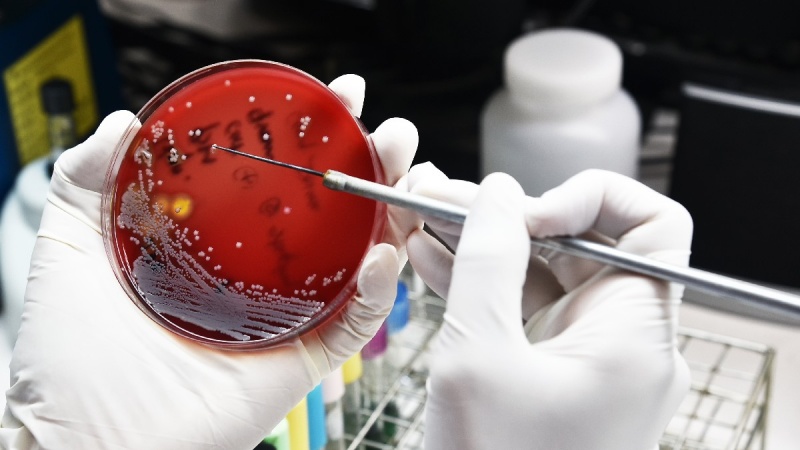

Διογκούμενο πρόβλημα τα ανθεκτικά στις υπάρχουσες αντιβιοτικές θεραπείες βακτήρια
14 Οκτωβρίου 2025, 07:00
Τα νοσοκομεία σε όλο τον κόσμο έχουν καταγράψει μια ανησυχητική αύξηση κοινών λοιμώξεων που είναι ανθεκτικές στα αντιβιοτικά, με τους γιατρούς να προειδοποιούν ότι ο αριθμός των θανάτων που προκαλούνται από την αντοχή στα φάρμακα θα αυξηθεί δραματικά τα επόμενα χρόνια. Μία στις έξι εργαστηριακά επιβεβαιωμένες βακτηριακές λοιμώξεις ήταν ανθεκτική στα αντιβιοτικά το 2023, ενώ περισσότερο από το 40% των αντιβιοτικών έχασαν την αποτελεσματικότητά τους έναντι κοινών λοιμώξεων του αίματος, του εντέρου, του ουροποιητικού συστήματος και των σεξουαλικώς μεταδιδόμενων νοσημάτων μεταξύ 2018 και 2023, σύμφωνα με τα διαθέσιμα στοιχεία.
Το πρόβλημα ήταν πιο σοβαρό και επιδεινούμενο στις χώρες χαμηλού και μεσαίου εισοδήματος, καθώς και σε εκείνες με πιο αδύναμα συστήματα υγείας, σύμφωνα με την Έκθεση Παγκόσμιας Επιτήρησης Αντοχής στα Αντιβιοτικά του Παγκόσμιου Οργανισμού Υγείας (ΠΟΥ), η οποία συγκέντρωσε δεδομένα για περισσότερες από 23 εκατομμύρια βακτηριακές λοιμώξεις από 104 χώρες.
«Τα ευρήματα αυτά είναι εξαιρετικά ανησυχητικά», δήλωσε ο Δρ. Yvan Hutin, διευθυντής του τμήματος αντοχής στα μικροβιακά φάρμακα του ΠΟΥ. «Καθώς η αντοχή στα αντιβιοτικά συνεχίζει να αυξάνεται, εξαντλούμε τις θεραπευτικές μας επιλογές και θέτουμε ζωές σε κίνδυνο, ιδίως σε χώρες όπου η πρόληψη και ο έλεγχος των λοιμώξεων είναι αδύναμα και η πρόσβαση σε διαγνωστικά και αποτελεσματικά φάρμακα ήδη περιορισμένη».
Οι εκτιμήσεις για ορισμένες χώρες ενδέχεται να είναι παραπλανητικές, καθώς ορισμένα συστήματα υγείας αναφέρουν δεδομένα μόνο από εξειδικευμένα νοσοκομεία που διαχειρίζονται τις πιο σοβαρές λοιμώξεις. Ωστόσο, με βάση τα συγκεντρωμένα στοιχεία, ο ΠΟΥ εκτιμά ότι μία στις τρεις βακτηριακές λοιμώξεις στη νοτιοανατολική Ασία και την ανατολική Μεσόγειο ήταν ανθεκτική στα αντιβιοτικά το 2023, ενώ στην Αφρική μία στις πέντε.
Η μικροβιακή αντοχή (AMR) εμφανίζεται όταν οι παθογόνοι μικροοργανισμοί εξελίσσονται ώστε να αντέχουν στα φάρμακα που χρησιμοποιούνται για την εξόντωσή τους. Το 2021, 7,7 εκατομμύρια άνθρωποι παγκοσμίως πέθαναν από βακτηριακές λοιμώξεις. Η αντοχή στα φάρμακα συνέβαλε σε 4,71 εκατομμύρια από αυτούς τους θανάτους, με 1,14 εκατομμύρια να αποδίδονται άμεσα σε αυτήν.
Η έκθεση εκφράζει σοβαρές ανησυχίες για τα Gram-αρνητικά βακτήρια εκείνα που προστατεύονται από ένα εξωτερικό περίβλημα, όπως το Escherichia coli και το Klebsiella pneumoniae, τα οποία προκαλούν μερικές από τις πιο σοβαρές βακτηριακές λοιμώξεις που συχνά οδηγούν σε σήψη, ανεπάρκεια οργάνων και θάνατο.
Ο Hutin δήλωσε ότι το 40% των στελεχών του E. coli και πάνω από το 55% του K. pneumoniae είναι ανθεκτικά στις κεφαλοσπορίνες τρίτης γενιάς, που αποτελούν την πρώτη επιλογή θεραπείας για τέτοιες λοιμώξεις. Στην αφρικανική περιοχή του ΠΟΥ, η αντοχή υπερβαίνει συχνά το 70%.
Ο Δρ. Manica Balasegaram, από το Global Antibiotic Research and Development Partnership, δήλωσε ότι η έκθεση προσθέτει αποδείξεις πως οι ανθεκτικές λοιμώξεις έχουν φτάσει σε «κρίσιμο σημείο καμπής».
«Οι πιο δύσκολες στη θεραπεία Gram-αρνητικές λοιμώξεις αρχίζουν τώρα να ξεπερνούν την ανάπτυξη αντιβιοτικών, είτε επειδή τα κατάλληλα αντιβιοτικά δεν φτάνουν στους ανθρώπους που τα χρειάζονται, είτε επειδή δεν αναπτύσσονται καθόλου», είπε. «Ως αποτέλεσμα, ο αριθμός των θανάτων που οφείλονται στην AMR αναμένεται να αυξηθεί απότομα, κατά 70% έως το 2050».
«Δεν αρκεί να αναπτύσσουμε νέα αντιβιοτικά· πρέπει να είναι τα σωστά, εκείνα που στοχεύουν λοιμώξεις με τον μεγαλύτερο αντίκτυπο στη δημόσια υγεία. Αποτυγχάνουμε να αντικαταστήσουμε τα αντιβιοτικά που χάνονται λόγω αντοχής, και η τελευταία έκθεση του ΠΟΥ δείχνει ότι οι συνέπειες αυτής της αποτυχίας αρχίζουν πλέον να γίνονται αισθητές».
«Μέχρι τώρα, η συζήτηση γύρω από την AMR επικεντρωνόταν, και σωστά, στην υπερβολική χρήση των αντιβιοτικών», πρόσθεσε, «όμως αυτό δεν αρκεί. Για να αποφύγουμε το σημείο καμπής, πρέπει να εστιάσουμε επίσης στην επιτάχυνση της καινοτομίας και στη σωστή χρήση των αντιβιοτικών».
Ο καθηγητής Sanjib Bhakta, ο οποίος εργάζεται πάνω στην ανάπτυξη φαρμάκων για την αντιμετώπιση της AMR στο University College London, δήλωσε ότι η έκθεση του ΠΟΥ αποκαλύπτει «μια ανησυχητική αύξηση της αντοχής», ιδίως μεταξύ των Gram-αρνητικών βακτηρίων.
Πρόσθεσε ότι η αντιμετώπιση της AMR απαιτεί «στοχευμένη παγκόσμια δράση», από την ενίσχυση της επιτήρησης και της διάγνωσης έως τη διασφάλιση δίκαιης πρόσβασης σε αντιβιοτικά στενού φάσματος. Η πρόληψη των λοιμώξεων είναι επίσης κρίσιμη μέσω καθαρότερου νερού, καλύτερης αποχέτευσης, υγιεινής και εμβολιασμού.
«Κρίσιμης σημασίας είναι επίσης η ανανέωση των επενδύσεων για τη στήριξη διεπιστημονικής, πρωτοποριακής έρευνας που στοχεύει στην ανακάλυψη νέων θεραπευτικών παρεμβάσεων κατά των ανθεκτικών στα φάρμακα βακτηρίων», δήλωσε.